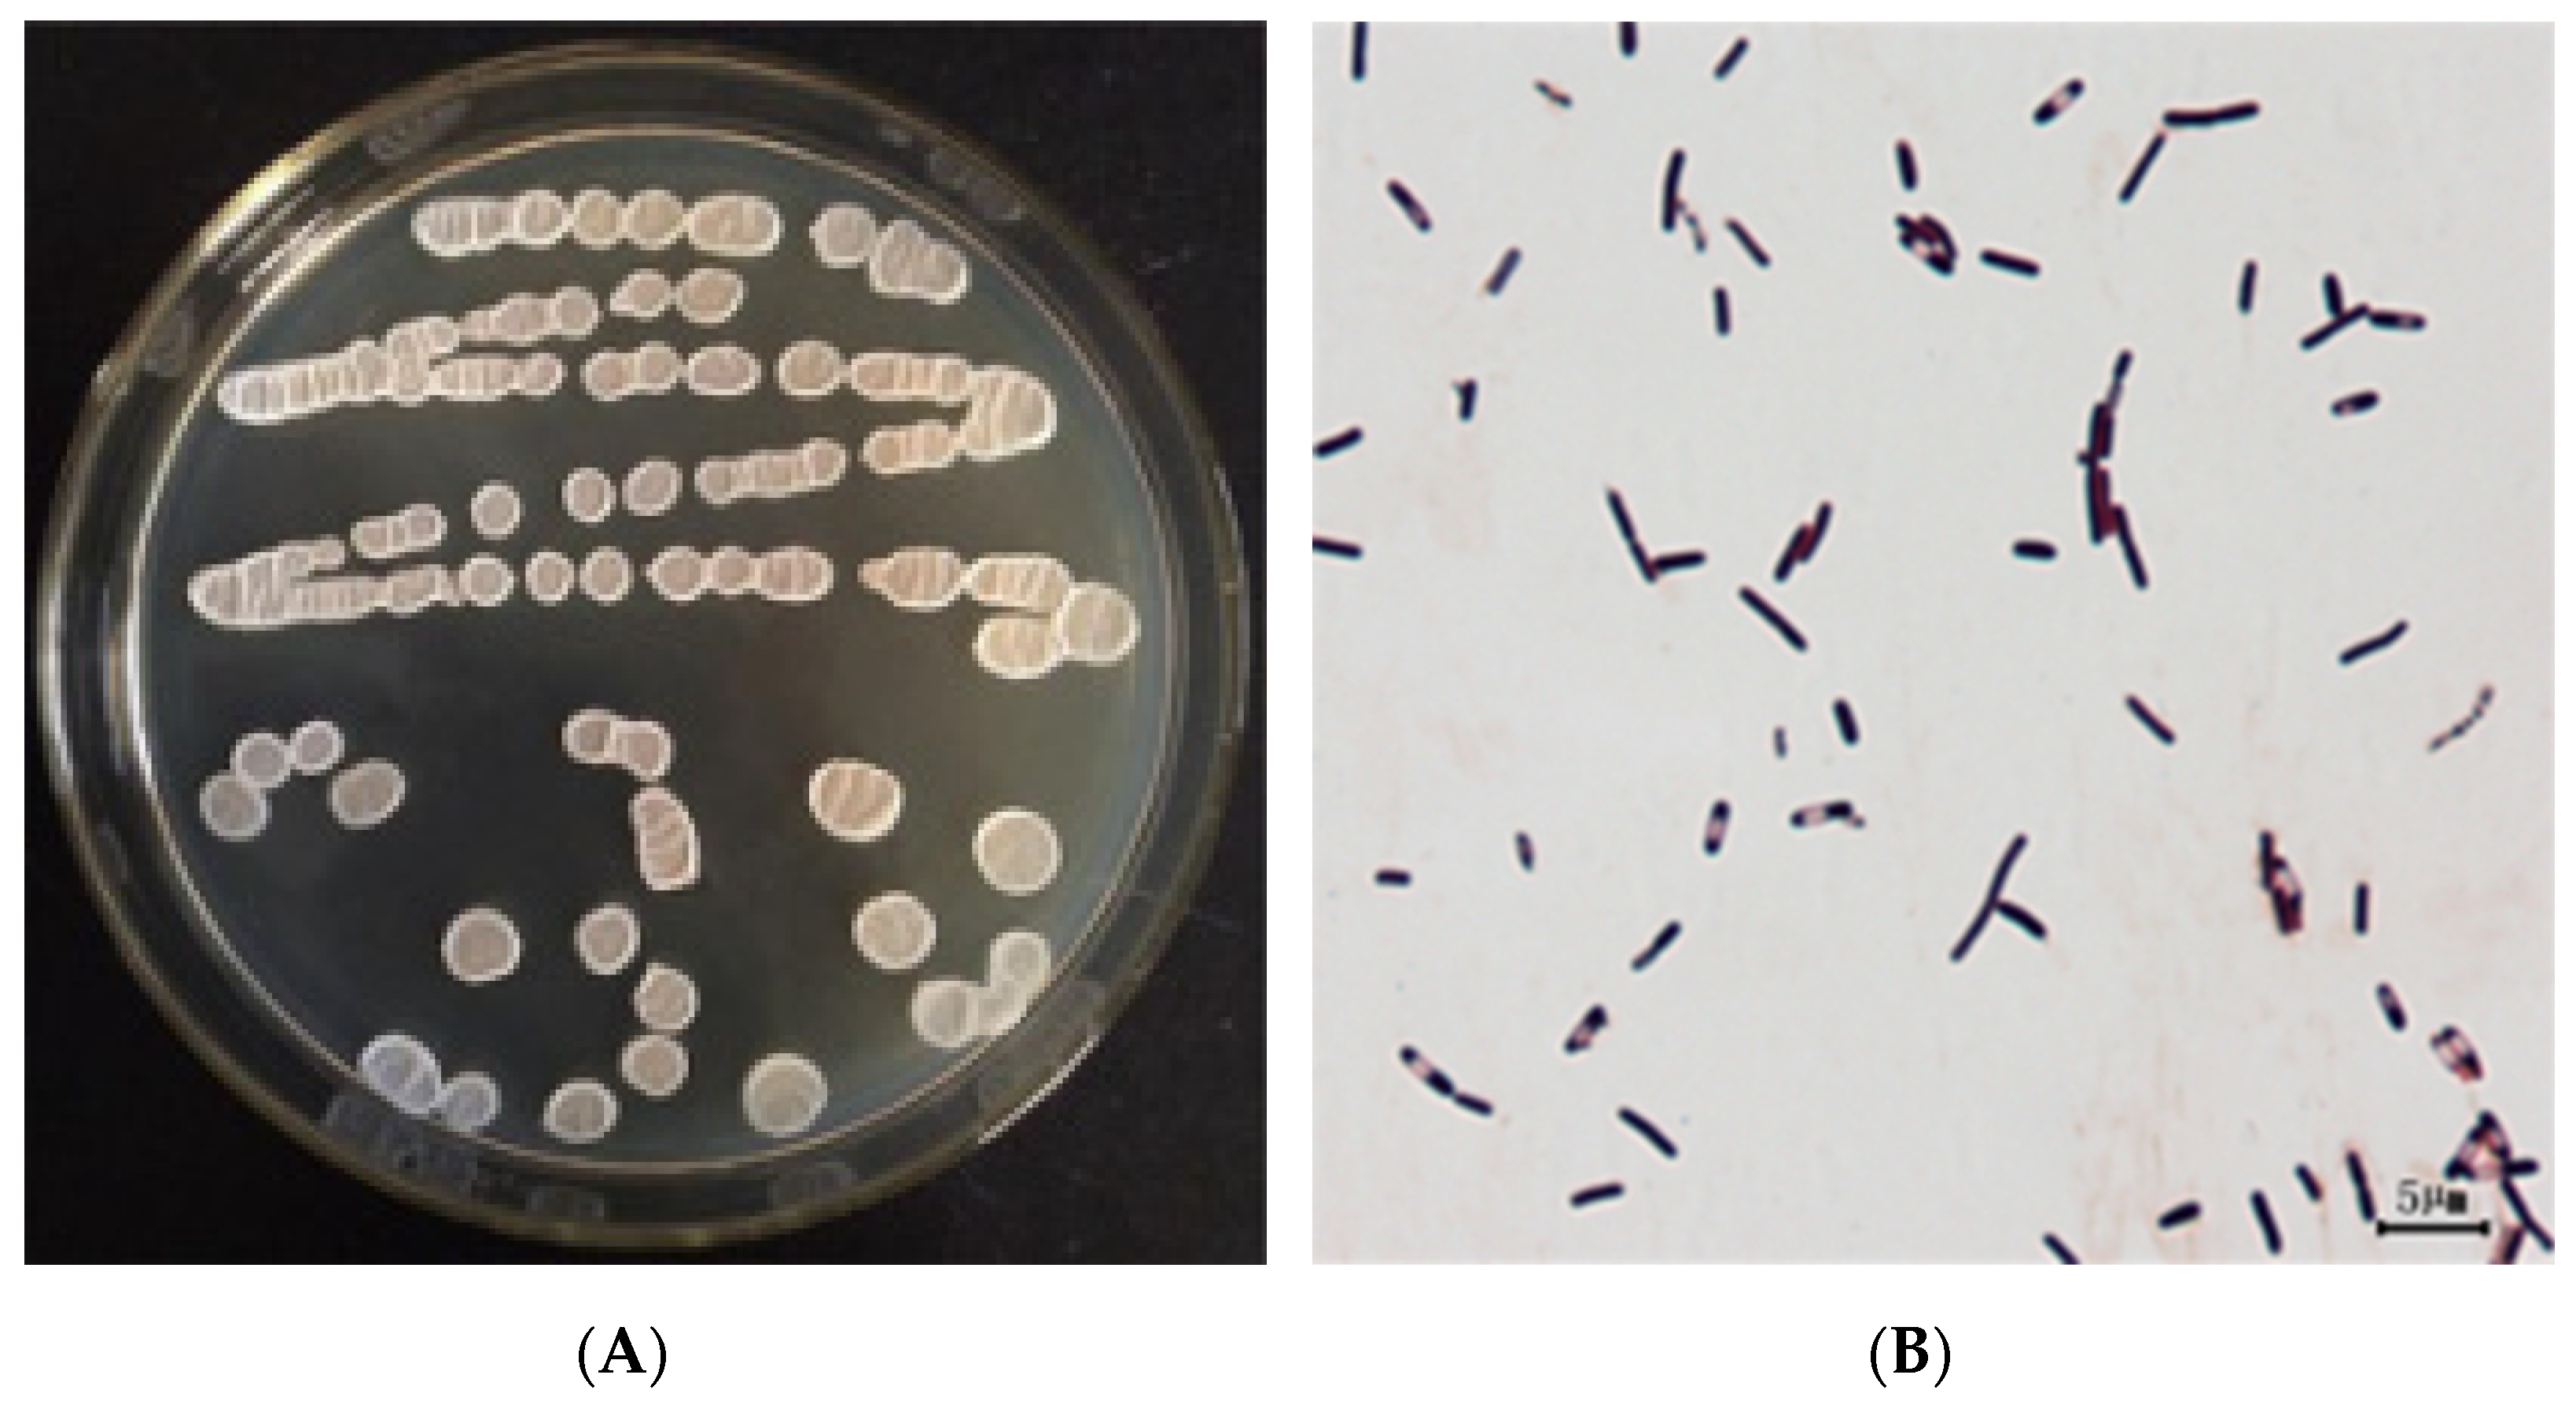
Agriculture 11 00581 g002

Bacillus velezensis WZ-37, a New Broad-Spectrum Biocontrol Strain, Promotes the Growth of Tomato Seedlings
Abstract
:1. Introduction
2. Materials and Methods
2.1. Experimental Strains and Plants
2.2. Isolation, Purification, and Screening of Biological Control Strains
2.3. Biopotential of Antipathogen Strain
2.4. Characterization of Biocontrol Strain
2.4.1. Morphological Observations
2.4.2. Morphological and Biochemical Indices of Strain WZ-37
2.4.3. 16S rRNA Sequence Analysis
2.5. Inhibition of Plant Pathogens’ Mycelial Growth by Biocontrol Bacteria
2.6. Effects of the Biocontrol Strain on Tomato Seeds and Seedling Growth
2.6.1. Seed Germination
2.6.2. Growth of Tomato Seedlings
2.7. Effect of Biological Control on Tomato B. cinerea in Greenhouse
2.8. Effect of Biocontrol Bacteria on Physiological Indices of Tomato Fruit
2.9. Statistical Analysis
3. Results
3.1. Isolation, Purification, and Screening of Biocontrol Bacteria Strains
3.2. Morphological, Physiological, Biochemical Characteristics, and Identification of Biocontrol Strain
3.2.1. Morphological Observations
3.2.2. Molecular Identification of the WZ-37 Strain
3.3. Inhibitory Effects of Strain WZ-37 upon Mycelial Growth
3.4. Effects of Strain WZ-37 Suspension on the Growth of Tomato Seeds and Seedlings
3.4.1. Tomato Seeds
3.4.2. Growth of Tomato Seedlings
3.5. Biocontrol Effect of WZ-37 against Tomato Gray Mold in the Greenhouse
3.6. Effect of Strain WZ-37 on the Physiological Indices of Tomato Fruits
4. Discussion
5. Conclusions
Supplementary Materials
Author Contributions
Funding
Institutional Review Board Statement
Informed Consent Statement
Data Availability Statement
Conflicts of Interest
Compliance with Ethical Standards
References
- Fisher, M.C.; Henk, D.A.; Briggs, C.J.; Brownstein, J.S.; Madoff, L.C.; Mccraw, S.L.; Gurr, S.J. Emerging fungal threats to animal, plant and ecosystem health. Nature 2012, 484, 186–194. [Google Scholar] [CrossRef]
- Elad, Y.; Pertot, I.; Prado, A.M.C.; Stewart, A. Plant hosts of Botrytis spp. In Botrytis the Fungus, the Pathogen and Its Management in Agricultural Systems; Fillinger, S., Elad, Y., Eds.; Springer: Berlin/Heidelberg, Germany, 2015; pp. 413–486. [Google Scholar]
- Lemonnier, P.; Gaillard, C.; Veillet, F.; Verbeke, J.; Lemoine, R.; Coutos-Thevenot, P.; La-Camera, S. Expression of Arabidopsis sugar transport protein STP13 differentially affects glucose transport activity and basal resistance to Botrytis cinerea. Plant Mol. Biol. 2014, 85, 473–484. [Google Scholar] [CrossRef]
- Badawy, M.E.I.; Rabea, E.I. Potential of the biopolymer chitosan with different molecular weights to control postharvest gray mold of tomato fruit. Postharvest Biol. Technol. 2009, 51, 110–117. [Google Scholar] [CrossRef]
- Williamson, B.; Tudzynski, B.; Tudzynski, P.; Van-Kan, J.A.L. Botrytis cinerea: The cause of grey mould disease. Mol. Plant Pathol. 2007, 8, 561–580. [Google Scholar] [CrossRef]
- Masmoudi, F.; Ben-Khedher, S.; Kamoun, A.; Zouari, N.; Tounsi, S.; Trigui, M. Combinatorial effect of mutagenesis and medium component optimization on Bacillus amyloliquefaciens antifungal activity and efficacy in eradicating Botrytis cinerea. Microbioll. Res. 2017, 197, 29–38. [Google Scholar] [CrossRef]
- Walker, A.S.; Gautier, A.; Confais, J.; Martinho, D.; Viaud, M.; Le-Pecheur, P.; Dupont, J.; Fournier, E. Botrytis pseudocinerea, a new cryptic species causing gray mold in french vineyards in sympatry with Botrytis cinerea. Phytopathology 2011, 101, 1433–1445. [Google Scholar] [CrossRef] [PubMed] [Green Version]
- Lee, J.P.; Lee, S.W.; Kim, C.S.; Son, J.H.; Song, J.H.; Lee, K.Y.; Kim, H.J.; Jung, S.J.; Moon, B.J. Evaluation of formulations of Bacillus licheniformis for the biological control of tomato gray mold caused by Botrytis cinerea. Biol. Control 2006, 37, 329–337. [Google Scholar] [CrossRef]
- Van-Kan, J.A.L.; Shaw, M.A.; Grant-Downton, R.T. Botrytis species: Relentless necrotrophic thugs or endophytes gone rogue? Mol. Plant Pathol. 2014, 15, 957–961. [Google Scholar] [CrossRef]
- Sowley, E.N.K.; Dewey, F.M.; Shaw, M.W. Persistent, symptomless, systemic, and seed-borne infection of lettuce by Botrytis cinerea. Eur. J. Plant Pathol. 2009, 126, 61–71. [Google Scholar] [CrossRef] [Green Version]
- Van-Kan, J.A.L.; Stassen, J.H.M.; Mosbach, A.; Van-der-Lee, T.A.J.; Faino, L.; Farmer, A.D.; Papasotiriou, D.G.; Zhou, S.G.; Seidl, M.F.; Cottam, E.; et al. A gapless genome sequence of the fungus Botrytis cinerea. Mol. Plant Pathol. 2017, 18, 75–89. [Google Scholar] [CrossRef] [Green Version]
- Hahn, M. The rising threat of fungicide resistance in plant pathogenic fungi: Botrytis as a case study. J. Chem. Biol. 2014, 7, 133–141. [Google Scholar] [CrossRef] [PubMed] [Green Version]
- Touré, Y.; Ongena, M.; Jacques, P.; Guiro, A.; Thonart, P. Role of lipopeptides produced by Bacillus subtilis GA1 in the reduction of grey mould disease caused by Botrytis cinerea on apple. J. Appl. Microbiol. 2010, 96, 1151–1160. [Google Scholar] [CrossRef] [PubMed]
- Raaijmakers, J.M.; Vlami, M.; Souza, J.T.D. Antibiotic production by bacterial biocontrol agents. Antonie Van Leeuwenhoek 2002, 81, 537–547. [Google Scholar] [CrossRef]
- Walker, R.; Powell, A.A.; Seddon, B. Bacillus isolates from the spermosphere of peas and dwarf French beans with antifungal activity against Botrytis cinerea and Pythium species. J. Appl. Microbiol. 2010, 84, 791–801. [Google Scholar] [CrossRef]
- Nobutaka, S. Biological control of fungal plant diseases using antagonistic bacteria. J. Gen. Plant Pathol. 2008, 74, 459–460. [Google Scholar]
- Chen, C.; Cao, Z.; Li, J.; Tao, C.; Feng, Y.N.; Han, Y.L. A novel endophytic strain of Lactobacillus plantarum CM-3 with antagonistic activity against Botrytis cinerea on strawberry fruit. Biol. Control. 2020, 148, 104306. [Google Scholar] [CrossRef]
- Sharma, R.R.; Singh, D.; Singh, R. Biological control of postharvest diseases of fruits and vegetables by microbial antagonists: A review. Biol. Control 2009, 50, 205–221. [Google Scholar] [CrossRef]
- Wisniewski, M.; Droby, S.; Norelli, J.; Liu, J.; Schena, L. Alternative management technologies for postharvest disease control: The journey from simplicity to complexity. Postharvest Biol. Technol. 2016, 122, 3–10. [Google Scholar] [CrossRef]
- Sujarit, K.; Pathom-aree, W.; Mori, M.; Dobashi, K.; Shiomi, K.; Lumyong, S. Streptomyces palmae CMU-AB204T, an antifungal producing-actinomycete, as a potential biocontrol agent to protect palm oil producing trees from basalstem rot disease fungus, Ganoderma boninense. Biol. Control 2020, 148, 104307. [Google Scholar] [CrossRef]
- Rini, C.R.; Sulochana, K.K. Usefulness of Trichoderma and Pseudomonas against Rhizoctonia solani and Fusarium oxysporum infecting tomato. J. Trop Agric. 2007, 45, 21–28. [Google Scholar]
- Zhong, Z.J.; Bi, Q.Y.; Wu, J.; Lu, F.; Han, X.Y.; Wang, W.Q. Occurrence and management of fungicide resistance in Botrytis cinerea on tomato from greenhouses in Hebei; China. J. Phytopathol. 2019, 167, 413–421. [Google Scholar]
- Zhang, H.Y.; Godana, E.A.; Sui, Y.; Yang, Q.Y.; Zhang, X.Y.; Zhao, L. Biological control as an alternative to synthetic fungicides for the management of grey and blue mould diseases of table grapes: A review. Crit. Rev. Microbiol. 2020, 46, 450–462. [Google Scholar] [CrossRef]
- Wang, H.; Shi, Y.Y.; Wang, D.D.; Yao, Z.T.; Wang, Y.M.; Liu, J.Y.; Zhang, S.M.; Wang, A.X. A Biocontrol strain of Bacillus subtilis WXCDD105 used to control tomato Botrytis cinerea and Cladosporium fulvum cooke and promote the growth of seedlings. Int. J. Mol. Sci. 2018, 19, 1371. [Google Scholar] [CrossRef] [Green Version]
- Li, B.; Xu, L.H.; Lou, M.M.; Li, F.; Zhang, Y.D.; Xie, G.L. Isolation and characterization of antagonistic bacteria against bacterial leaf spot of euphorbia Pulcherrima. Lett. Appl. Microbiol. 2010, 46, 450–455. [Google Scholar] [CrossRef] [PubMed]
- Cappuccino, J.G.; Sherman, N. Microbiology: A Laboratory Manual, 8th ed.; Pearson Benjamin Cummings: San Francisco, CA, USA, 2008; pp. 1–9. [Google Scholar]
- Lee, S.; Oneda, H.; Minoda, M.; Tanaka, A.; Inouye, K. Comparison of starch hydrolysis activity and thermal stability of two Bacillus licheniformis α-amylases and insights into engineering α-amylase variants active under acidic conditions. J. Biochem. 2006, 139, 997–1005. [Google Scholar] [CrossRef]
- Ji, B.; Yang, K.; Wang, H.Y.; Zhou, J.; Zhang, H.N. Aerobic denitrification by Pseudomonas stutzeri C3 incapable of heterotrophic nitrification. Bioprocess Biosyst. Eng. 2015, 38, 407–409. [Google Scholar] [CrossRef]
- Yang, Q.; Franco, C.M.M.; Zhang, W. Sponge-associated actinobacterial diversity: Validation of the methods of actinobacterial DNA extraction and optimization of 16S rRNA gene amplification. Appl. Microbiol. Biot. 2015, 99, 8731–8740. [Google Scholar] [CrossRef]
- Wu, R.J.; Wang, X.H.; Liu, Z.M.; Liu, Z.P.; Hu, H.; Ma, H.P. Isolation, identification and interaction of rhizosphere microorganisms involved in peach replant diseases. Sci. Agric. Sin. 2009, 42, 1631–1638. [Google Scholar]
- Mussa, A.; Million, T.; Assefa, F. Rhizospheric bacterial isolates of grass pea (Lathyrus sativus L.) endowed with multiple plant growth promoting traits. J. Appl. Microbiol. 2018, 125, 1786–1801. [Google Scholar] [CrossRef]
- Kim, H.J.; Lee, S.H.; Kim, C.S.; Lim, E.K.; Choi, K.H.; Kong, H.G.; Kim, D.W.; Lee, S.W.; Moon, B.J. Biological control of strawberry gray mold caused by Botrytis cinerea using Bacillus licheniformis N1 formulation. J. Microbiol. Biotechnol. 2007, 17, 438–444. [Google Scholar]
- Fang, Z. Research Methods of Plant Disease; Chinese Agricultural Press: Beijing, China, 2007; pp. 253–254. [Google Scholar]
- Kasfi, K.; Taheri, P.; Jafarpour, B.; Tarighi, S. Characterization of antagonistic microorganisms against Aspergillus spp. from grapevine leaf and berry surfaces. J. Plant Pathol. 2018, 100, 1–12. [Google Scholar] [CrossRef]
- Wu, Y.J.; Lin, H.T.; Lin, Y.F.; Shi, J.; Xue, S.; Hung, Y.C.; Chen, Y.H.; Wang, H. Effects of biocontrol bacteria Bacillus amyloliquefaciens LY-1 culture broth on quality attributes and storability of harvested litchi fruit. Postharvest Biol. Technol. 2017, 132, 81–87. [Google Scholar] [CrossRef]
- Oregel-Zamudio, E.; Angoa-Pérez, M.V.; Oyoque-Salcedo, G.; Aguilar-González, C.N.; Mena-Violante, H.G. Effect of candelilla wax edible coatings combined with biocontrol bacteria on strawberry quality during the shelf-life. Sci. Hortic. 2017, 214, 273–279. [Google Scholar] [CrossRef]
- Rabbee, M.F.; Ali, M.S.; Choi, J.; Hwang, B.S.; Jeong, S.C.; Baek, K.H. Bacillus velezensis: A valuable member of bioactive molecules within plant microbiomes. Molecules 2019, 24, 1046. [Google Scholar] [CrossRef] [Green Version]
- Ruiz-Garcia, C.; Bejar, V.; Martinez-Checa, F.; Llamas, I.; Quesasa, E. Bacillus velezensis sp. nov., A surfactant-producing bacterium isolated from the River Vélez in Málaga, Southern Spain. Int. J. Syst. Evol. Microbiol. 2005, 55, 191–195. [Google Scholar] [CrossRef] [PubMed] [Green Version]
- Gao, Z.; Zhang, B.; Liu, H.; Han, J.; Zhang, Y. Identification of endophytic Bacillus velezensis ZSY-1 strain and antifungal activity of its volatile compounds against alternaria solani and Botrytis cinerea. Biol. Control 2017, 105, 27–39. [Google Scholar] [CrossRef]
- Errington, J. Bacillus subtilis sporulation: Regulation of gene expression and control of morphogenesis. Microbiol. Rev. 1993, 57, 1–33. [Google Scholar] [CrossRef] [PubMed]
- Palazzini, J.M.; Dunlap, C.A.; Bowman, M.J. Bacillus velezensis RC 218 as a biocontrol agent to reduce Fusarium head blight and deoxynivalenol accumulation genome sequencing and secondary metabolite cluster profiles. Microbiol. Res. 2016, 192, 30–36. [Google Scholar] [CrossRef]
- Chen, Z.; Huang, J.; Zhao, J.; Liang, H. Isolation and identification of pathogenic fungus of and screening of antagonistic bacteria against tomato gray mold. Biotechnol. Bull 2017, 33, 81–87. [Google Scholar]
- Calvo, H.; Mendiara, I.; Arias, E.; Gracia, A.P.; Blanco, D.; Venturini, M.E. Antifungal activity of the volatile organic compounds produced by Bacillus velezensis strains against postharvest fungal pathogens. Postharvest Biol. Technol. 2020, 166, 111208. [Google Scholar] [CrossRef]
- Harun-Or-Rashid, M.; Khan, A.; Hossain, M.T.; Chung, Y.R. Induction of systemic resistance against aphids by endophytic Bacillus velezensis YC7010 via expressing PHYTOALEXIN DEFICIENT4 in Arabidopsis. Front. Plant Sci. 2017, 8, 211. [Google Scholar]
- Choi, T.G.; Maung, C.E.H.; Lee, D.R.; Henry, A.B.; Lee, Y.S.; Kim, K.Y. Role of bacterial antagonists of fungal pathogens, Bacillus thuringiensis KYC and Bacillus velezensis CE 100 in control of root-knot nematode, Meloidogyne incognita and subsequent growth promotion of tomato. Postharvest Biol. Technol. 2020, 30, 685–700. [Google Scholar] [CrossRef]
- Chen, X.H.; Koumoutsi, A.; Scholz, R.; Eisenreich, A.; Schneider, K.; Heinemeyer, I.; Morgenstern, B.; Voss, B.; Hess, W.R.; Reva, O.; et al. Comparative analysis of the complete genome sequence of the plant growth-promoting bacterium Bacillus amyloliquefaciens FZB42. Nat. Biotechnol. 2007, 25, 1007–1014. [Google Scholar] [CrossRef] [Green Version]
- Fan, B.; Blom, J.; Klenk, H.P.; Borriss, R. Bacillus amyloliquefaciens, Bacillus velezensis, and Bacillus siamensis form an “operational group B. amyloliquefaciens” within the B. subtilis species complex. Front. Microbiol. 2017, 8, 1–15. [Google Scholar] [CrossRef] [Green Version]
- Guo, S.; Li, X.; He, P.; Ho, H.; Wu, Y.; He, Y. Whole-genome sequencing of Bacillus subtilis XF-1 reveals mechanisms for biological control and multiple beneficial properties in plants. J. Ind. Microbiol. Biotechnol. 2015, 42, 925–937. [Google Scholar] [CrossRef]
- Rückert, C.; Blom, J.; Chen, X.H.; Reva, O.; Borriss, R. Genome sequence of B. amyloliquefaciens type strain DSM7T reveals differences to plant-associated B. amyloliquefaciens FZB42. J. Biotechnol. 2011, 155, 78–85. [Google Scholar] [CrossRef]
- Xu, T.; Zhu, T.; Li, S. β-1,3-1,4-glucanase gene from Bacillus velezensis ZJ20 exerts antifungal effect on plant pathogenic fungi. World J. Microb. Biot. 2016, 32, 1–9. [Google Scholar] [CrossRef]
- Harun-Or-Rashid, M.; Hwang, J.H.; Chung, Y.R. Copmlete genome sequence of Bacillus velezensis YC7010, an endophytic bacterium with plant growth promoting, antimicrobial and systemic resistance inducing activities in rice. Korean J. Microbiol. 2017, 53, 329–331. [Google Scholar]
- Peng, G.; Zhao, X.Y.; Li, Y.Z.; Wang, R.; Huang, Y.; Qi, G.F. Engineering Bacillus velezensis with high production of acetoin primes strong induced systemic resistance in Arabidopsis thaliana. Microbiol. Res. 2019, 227, 1–12. [Google Scholar] [CrossRef]
- Sang, Y.K.; Sang, Y.L.; Weon, H.Y.; Sang, M.K.; Song, J. Complete genome sequence of Bacillus velezensis M75, a biocontrol agent against fungal plant pathogens, isolated from cotton waste. J. Biotechnol. 2017, 241, 112–115. [Google Scholar]
- Korir, H.; Mungai, N.W.; Thuita, M.; Hamba, Y.; Masso, C. Co-inoculation effect of rhizobia and plant growth promoting rhizobacteria on common bean growth in a low phosphorus soil. Front. Plant Sci. 2017, 8, 141. [Google Scholar] [CrossRef] [PubMed] [Green Version]
- Sundaramoorthy, S.; Raguchander, T.; Ragupathi, N.; Samiyappan, R. Combinatorial effect of endophytic and plant growth promoting rhizobacteria against wilt disease of Capsicum annum L. caused by Fusarium solani. Biol. Control 2012, 60, 59–67. [Google Scholar] [CrossRef]
- Meng, Q.; He, J.; Hao, J.J. Effects of Bacillus velezensis strain BAC03 in promoting plant growth. Biol. Control 2016, 98, 18–26. [Google Scholar] [CrossRef]

| Strain Number | Inhibition Zone/mm | ||
|---|---|---|---|
| WD1 | WS3 | FO | |
| 37 | 8.50 ± 0.57 a | 8.00 ± 0.51 a | 9.00 ± 0.68 a |
| 85 | 8.00 ± 0.49 a | 3.00 ± 0.48 b | 2.50 ± 0.37 b |
| 101 | 6.00 ± 0.39 b | 1.50 ± 0.29 c | 1.50 ± 0.31 bc |
| 89 | 3.50 ± 0.41 c | 1.00 ± 0.29 c | 1.00 ± 0.27 c |
| 169 | 3.00 ± 0.40 c | 0.50 ± 0.23 c | 1.00 ± 0.29 c |
| 116 | 3.00 ± 0.11 c | 0.50 ± 0.11 c | 0.50 ± 0.11 c |
| Strain | WD1 | FK | CL | WS3 | |
|---|---|---|---|---|---|
| WZ-37 | Mycelium Dry Weight (mg) | 14.00 ± 1.78 a | 23.00 ± 2.04 a | 22.00 ± 1.78 a | 16.00 ± 2.12 a |
| Inhibition Rate (%) | 96.97 | 93.82 | 95.59 | 96.38 | |
| WXCDD105 | Mycelium Dry Weight (mg) | 15.00 ± 1.87 a | 65.00 ± 2.04 b | 95.00 ± 1.78 b | 117.00 ± 2.86 b |
| Inhibition Rate (%) | 96.75 | 82.53 | 80.96 | 73.53 | |
| CK | Mycelium Dry Weight (mg) | 462.00 ± 24.91 b | 372.00 ± 15.12 c | 499.00 ± 28.08 c | 442.00 ± 23.72 c |
| Inhibition Rate (%) | - | - | - | - |
| Treatment | Height/mm | Stem Diameter/mm | Fresh Weight/g | Dry Weight/g |
|---|---|---|---|---|
| WZ-37 | 69.65 ± 0.60 a | 1.51 ± 0.03 a | 0.25 ± 0.02 a | 0.016 ± 0.02 a |
| CK | 56.35 ± 0.46 b | 1.28 ± 0.03 b | 0.18 ± 0.03 b | 0.012 ± 0.01 b |
| Treatment | Disease Index % | Control Efficiency % |
|---|---|---|
| B | 52.59 ± 0.71 a | - |
| WB | 20.95 ± 0.57 c | 60.16% |
| BW | 26.67 ± 0.74 c | 49.29% |
| XB | 23.33 ± 0.72 b | 55.64% |
| BX | 28.15 ± 0.59 b | 46.47% |
Publisher’s Note: MDPI stays neutral with regard to jurisdictional claims in published maps and institutional affiliations. |
© 2021 by the authors. Licensee MDPI, Basel, Switzerland. This article is an open access article distributed under the terms and conditions of the Creative Commons Attribution (CC BY) license (https://creativecommons.org/licenses/by/4.0/).
Share and Cite
Chen, X.; Huang, H.; Zhang, S.; Zhang, Y.; Jiang, J.; Qiu, Y.; Liu, J.; Wang, A. Bacillus velezensis WZ-37, a New Broad-Spectrum Biocontrol Strain, Promotes the Growth of Tomato Seedlings. Agriculture 2021, 11, 581. https://doi.org/10.3390/agriculture11070581
Chen X, Huang H, Zhang S, Zhang Y, Jiang J, Qiu Y, Liu J, Wang A. Bacillus velezensis WZ-37, a New Broad-Spectrum Biocontrol Strain, Promotes the Growth of Tomato Seedlings. Agriculture. 2021; 11(7):581. https://doi.org/10.3390/agriculture11070581
Chicago/Turabian StyleChen, Xiuling, Haifeng Huang, Shumei Zhang, Yao Zhang, Jingbin Jiang, Youwen Qiu, Jiayin Liu, and Aoxue Wang. 2021. "Bacillus velezensis WZ-37, a New Broad-Spectrum Biocontrol Strain, Promotes the Growth of Tomato Seedlings" Agriculture 11, no. 7: 581. https://doi.org/10.3390/agriculture11070581






